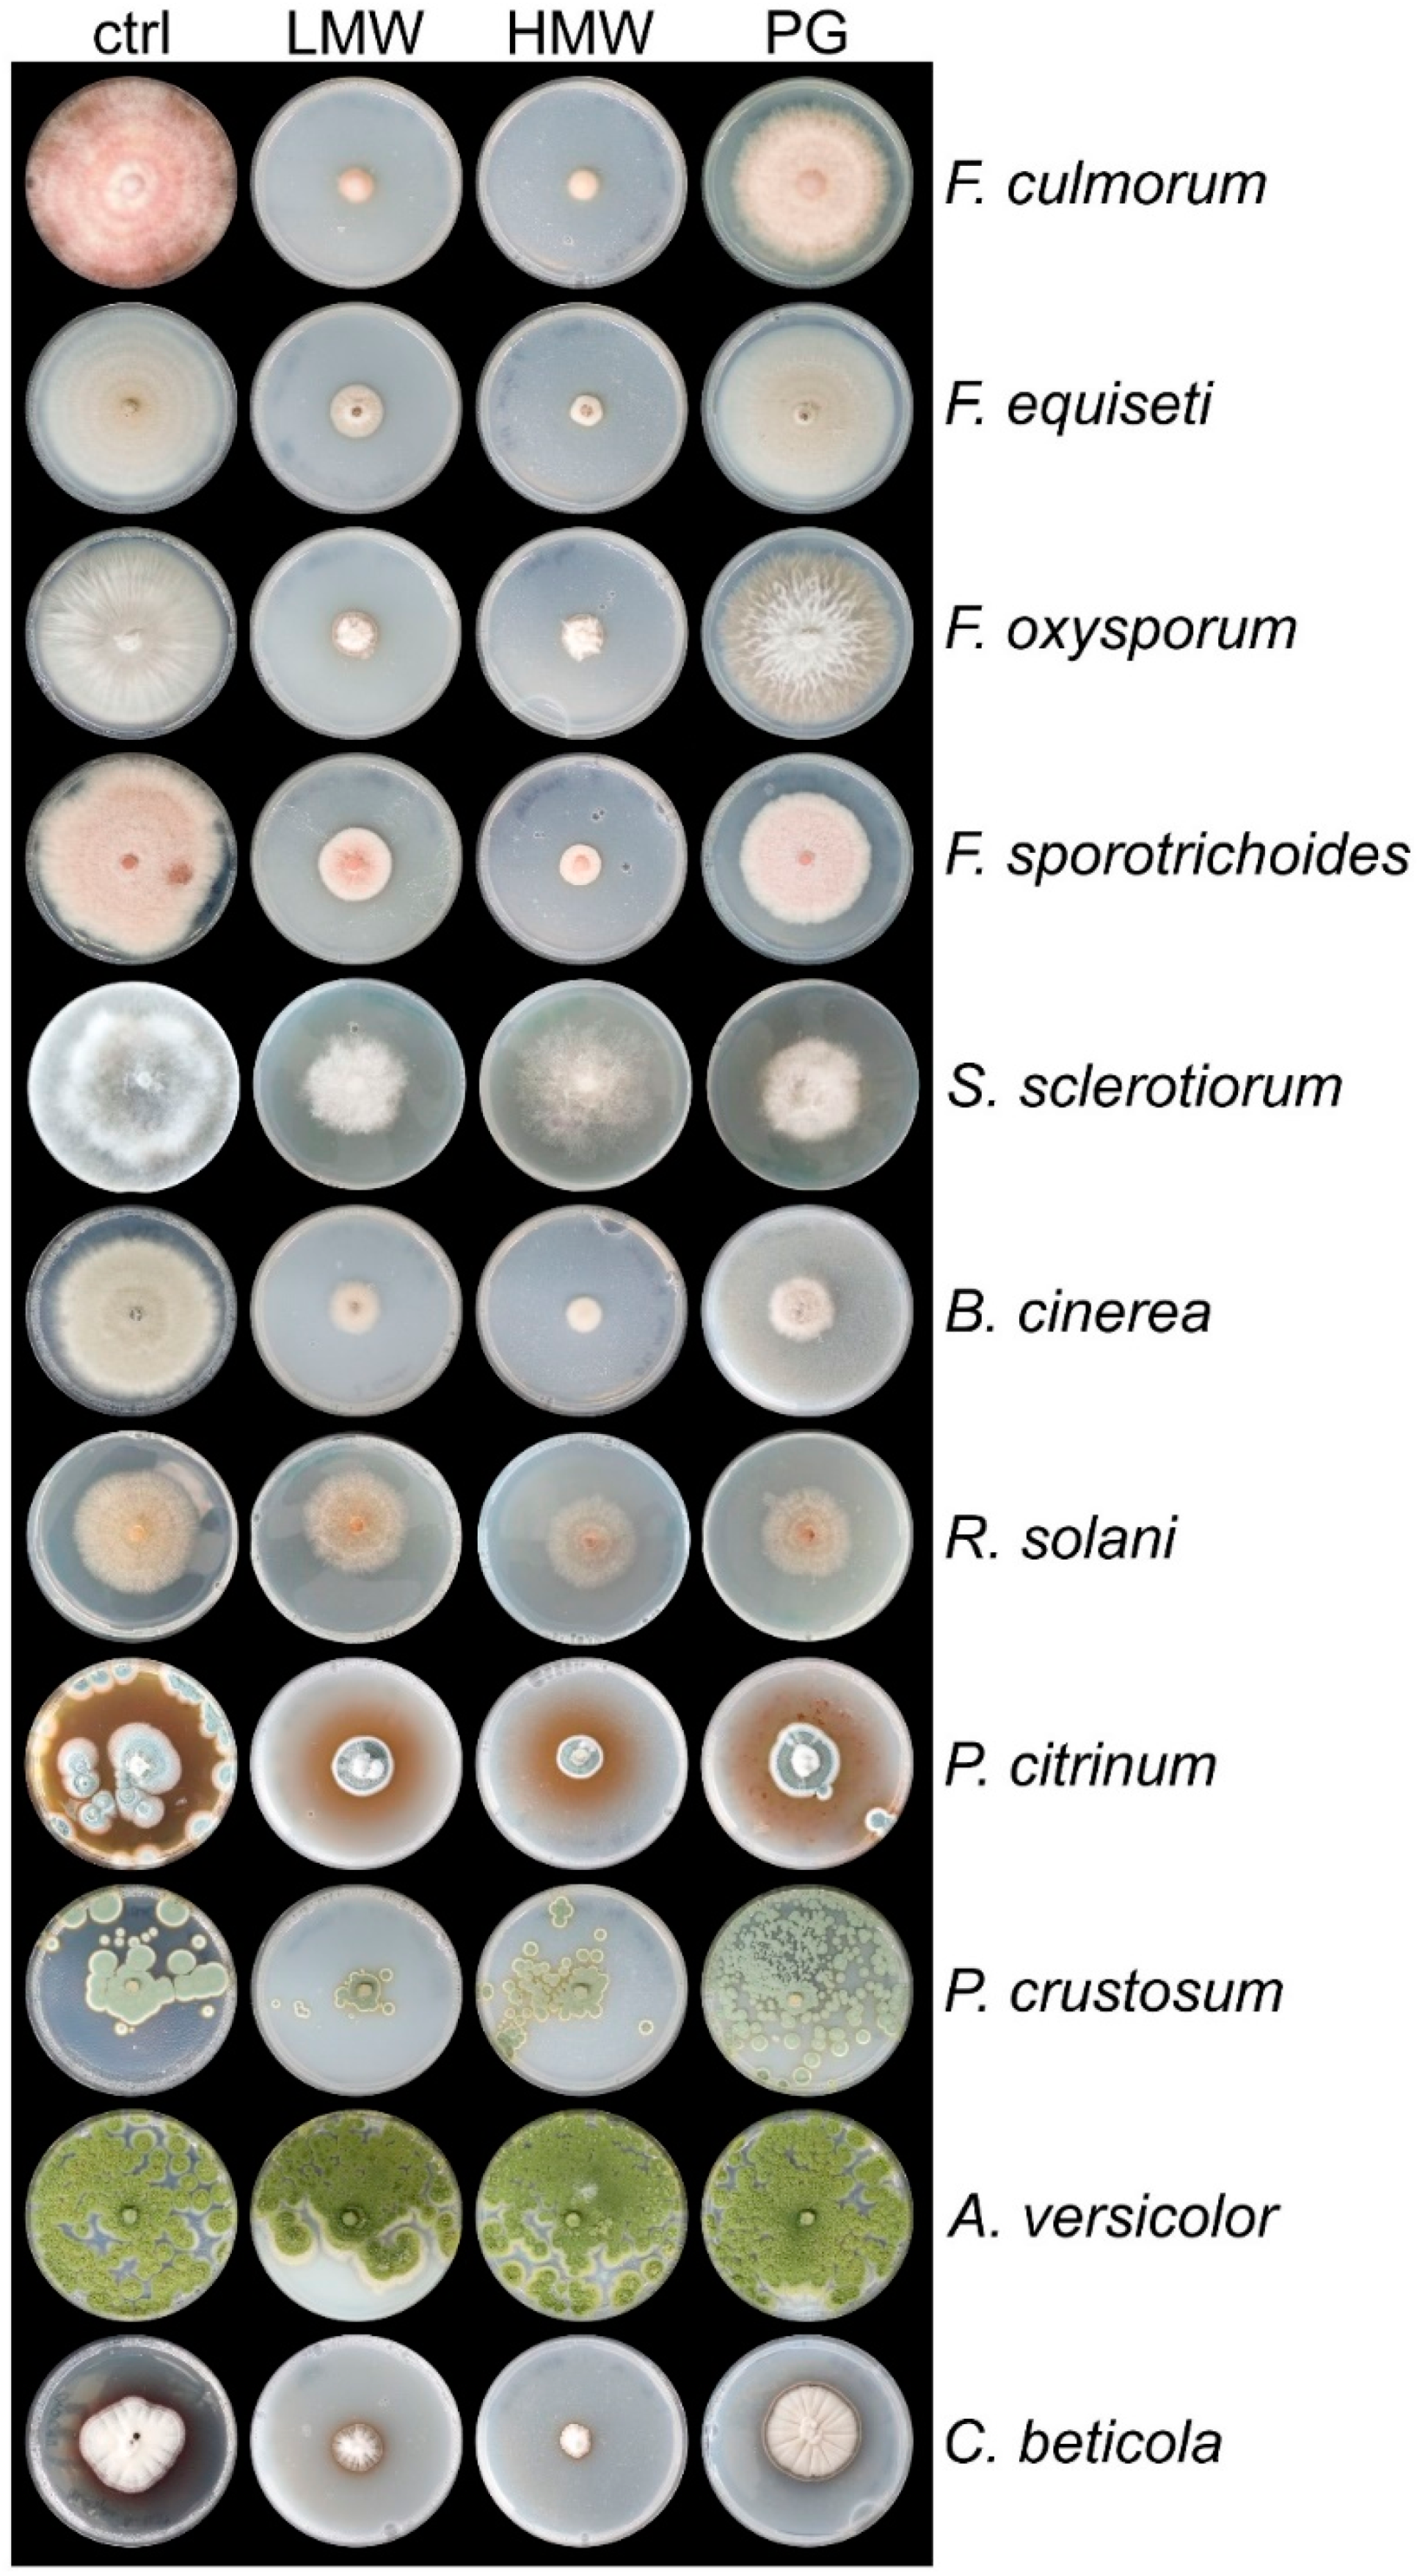
Jof 08 00137 g001 550

1. Introduction
The bioactive molecule chitosan (CHSN) is on everyone’s lips and is considered one of the most effective natural antimicrobial agents. The activity of chitosan depends on its molecular weight (degree of polymerization (DP) was several 100 kDa to oligo chitosans, such as hexamers); the degree of deacetylation (DA), which is dependent on the pH (at pH 6.0 most amino groups are in free base form); and the target microorganism (decreasing efficiency: yeast > mold > Gram-positive bacteria > Gram-negative bacteria). Proposed mechanisms include membrane destabilization and host permeability (reviewed in [
1]). Chito-oligosaccharides (
n = 2–10) and very-low-molecular-weight chitosans (
n ≤ 20) are mainly produced for therapeutic purposes, while the more viscous molecules (high molecular weight, HMW) are used for food and fiber technology [
2]. Importantly, chitosan and its derivatives are considered strong antimicrobial and plant-strengthening agents in crop protection (reviewed [
1]), comparable to biological control agents (BCAs), but their widespread application in industrial crop production is still pending. Due to the environmentally problematic production routes of chitosan and the poor understanding around cellular mechanism of action, there is a lack of broad applications in which potentially harmful substances, such as synthetic pesticides, could be substituted. A further benefit of using chitosan is its GRAS-status (generally recognized as safe), which would facilitate registration.
Systemic resistance induction of chitosan in plants has been studied over several years now (e.g., [
3,
4]). For instance, seed soaking, application on roots, or spraying of chitosan products elicit defense mechanisms in plants, thereby promoting pathogen resistance and concomitantly enhancing growth [
1,
2].
Trichoderma spp. are known to be promising tools in biocontrol. To this end, plant-beneficial
Trichoderma species are primarily defined by their antagonism against plant pathogens, activation of the plant defense system [
5] and as opportunistic plant symbionts that increase the systemic resistance of plants [
6]. In fact, almost 90% of fungal BCA formulations and more than 60% of bio-based fungicides contain
Trichoderma species [
7,
8] while
Trichoderma-based organic fertilizers are becoming increasingly widespread due to their easier registration [
9,
10].
Trichoderma spp. are applied as seed, soil, or foliar treatments [
5], bio-/mycofungicides, plant bio-stimulants [
8], and organic fertilizers. Applying
Trichoderma spp. to plants results in local and systemic defense reactions, which involves signaling cascades and activation as well as accumulation of defense-related antimicrobial compounds and enzymes in plants. The production of enzymes, such as pathogenesis-related (PR) proteins, phenyl ammonia lyase (PAL), and peroxidases, increased, and terpenoids, phytoalexins, and antioxidants (ascorbic acid, glutathione, etc.) are synthetized [
9,
11,
12,
13].
One of these promising BCAs is the mycoparasite
Trichoderma atroviride. Mycoparasitic responses are triggered by molecules released from the host fungus (components released by cell wall degradation) or through physical contact, accomplished through surface-located components (e.g., lectins) [
14].
T. atroviride inhibits or kills a host by hydrolyzing and parasitizing on its hyphae through cell wall degrading enzymes. Among these enzymes, the GH18 (endo-) chitinases (e.g.,
ech42 during engagement of
Trichoderma with
R. solani,
chi 18-1, and
chi18-13), proteases (
prb1, coding for a unique serine protease), the
N-acetylglucosaminidase
nag1 [
15], as well as glucanases are considered indicators for mycoparasitic activity. Recently, we have discovered that cell wall modifying enzymes, such as chitin deacetylases, chitosanases, and chitin synthases, are involved in cell wall remodeling during mycoparasitism and significantly contribute to the mycoparasitic capabilities [
16]. This indicates that the first line of attack engaged by
T. atroviride involves enzymes that can compromise the host’s cell wall integrity by targeting the glucan matrix but also its chitinous backbone. Fungal-secreted cerato-platanins are used to communicate with the plant and induce phytoalexin production and/or plant cell death in host and non-host plants, and are suggested as virulence factors in plant pathogenic fungi [
17,
18]. From this family of proteins, EPL1 was the first described non-enzymatic protein with an elicitor function in
T. atroviride [
19]. Moreover, secondary metabolites, including peptides and volatile compounds [
20], act against fungal pathogens, by activating plant defense response to stress and/or improving plant root system morphology and physiology [
7,
10].
In recent years, a combination of BCAs with antimicrobial/biocidal compounds, such as chitosan, has become increasingly important [
21,
22]. In most of the studies, the combined effects of chitosan with other antimicrobial agents or BCAs are higher regarding the synergistic antimicrobial effects of chitosan. Particularly noteworthy for our study are the recently published results on the bio-efficacy of castor, groundnut, or safflower seeds, coated with a chitosan–polyethylene glycol
Trichoderma harzianum (CHSN-PEG-
Th) blend, which showed that the germination and vitality of the seedlings was significantly increased, but disease was reduced [
21,
23]. Moreover, a combination of chitosan (or a chitosan oligomer) and an albino strain of
T. harzianum inhibited spore germination and, hence, the colony formation of the plant pathogens
Leptographium procerum or
Sphaeropsis sapinea [
22].
Due to its high damaging potential, Cercospora leaf spot (CLS) disease caused by
Cercospora beticola (class Ascomycota, ord. Dothideales, fam. Mycosphaerellaceae) is a continuous threat to sugar beet production worldwide. CLS disease severely affects sugar refinery in more than a third of sugar beet areas worldwide [
24,
25]. In Austria, sugar beets (
Beta vulgaris ssp.
vulgaris) are mainly cultivated in the eastern parts of lower Austria. The conditions for the main growth period of
B. vulgaris in summer (June to August) are a warm, humid, continental, Pannonian climate with average temperature values of 18–20 °C, 80–90 mm monthly precipitation, and 10–11 h daily sunshine duration. These conditions and reduced or neglected crop rotation strategies promote the infestation with different fungal and insect-associated diseases.
The yield reduction due to CLS infestation is around 20 percent per year [
25,
26]. Usually CLS is combated by spraying the field with fungicides three to five times a year, negatively impacting the environment and the development of fungal resistance [
25]. Immediate, natural, and safe application with effective and improved control of CLS disease is thus urgently needed. In addition, due to the climate crisis, new efforts should be made to support agriculture with new scientific findings on ecological and biocontrol strategies.
Despite its strong plant-beneficial efficacy, only a few studies dealt with application of
Trichoderma strains to induced resistance against sugar beet pathogens so far [
27,
28,
29,
30,
31,
32] and only one investigated
Trichoderma as a potential BCA against CLS [
28]. In a recent study, the high potential of chitosan in combination with a commercially available resistance inducer (Acibenzolar-S-Methyl, ASM) as a foliar spray on table beet against CLS was demonstrated [
33].
In the present study, the ability of T. atroviride IMI206040 and chitosan to promote growth and induce defense mechanisms in B. vulgaris against pathogens (C. beticola, CLS) was evaluated in planta and in vitro. We investigated seed coating and foliar application of the BCA T. atroviride and chitosan. Furthermore, host specificity of important sugar beet pathogens, such as C. beticola, Fusarium spp., Penicillium spp., and Aspergillus versicolor, was determined by employing chitosans of different molecular weight. Moreover, the combined application of T. atroviride and chitosan was assayed via a three-way interaction in plate assays in vitro. Furthermore, the defense stimulation against CLS disease in a greenhouse pot experiment was investigated.
Our findings expand the knowledge on Trichoderma spp. and chitosan as potent BCAs for the investigated pathogenic fungi in sugar beet production. We intend to evaluate novel combinations of BCA and chitosan derivatives with regard to their advantages and disadvantages on field application. To this end, CHSN and T. atroviride combined or in alternating application will become very attractive, if our understanding of chitosan, and its individual, potentiating, or synergistic effects, will be confirmed in biocontrol trials on field.
2. Materials and Methods
2.1. Strains and Cultivation Conditions
Trichoderma atroviride IMI206040 was maintained on potato dextrose agar (PDA, BD, Franklin Lakes, NJ, USA) and incubated at 28 °C with a 12 h/12 h light cycle.
Fusarium culmorum,
F. equiseti,
F. oxysporum,
F. sporotrichoides,
Sclerotinia sclerotiorum,
Botrytis cinerea,
Rhizoctonia solani,
Penicillium citrinum,
P. crustosum, and
Aspergillus versicolor were maintained on PDA or malt extract (MEX, Roth, Karlsruhe, Germany) agar at 25 °C in the dark or stated otherwise.
S. sclerotiorum,
B. cinerea, and
R. solani have been described previously [
16,
34]. The isolate
Cercospora beticola 1437 is a verified isolate from a
B. vulgaris CLS from a sugar beet field in lower Austria. The fungus was maintained on Czapek-Dox agar or PDA at 25 °C or otherwise stated. All other pathogenic strains were kindly provided by Agrana Research and Innovation Center (ARIC, Tulln, Austria).
2.2. Chemicals and Kits
Chemicals were obtained from Roth (Carl Roth GmbH + Co. KG, Karlsruhe, Germany) and Sigma-Aldrich (Sigma-Aldrich, St. Louis, MO, USA). A commercial preparation of chitosan of crustacean origin with different molecular weights was purchased from Sigma-Aldrich, including low-molecular-weight (LMW, CAS Number: 448869; DP: 50–190 kDa (based on viscosity), DA: 75–85%), high-molecular-weight (HMW, CAS Number: 419419; DP: 310–375 kDa, DA: >75%), and practical-grade (PG, CAS Number: 417963; DP: 190–375 kDa, DA: ≥75%) chitosan. Enzymes and kits were obtained from Thermo Fisher (Thermo Fisher Scientific, Waltham, MA, USA), Promega (Promega Corporation, Fitchburg, WI, USA), QIAGEN (QIAGEN N. V., Venlo, The Netherlands), and Bio-Rad (Bio-Rad Laboratories, Hercules, CA, USA).
2.3. Cultivation Conditions for T. atroviride and Plant Pathogenic Fungi on Plates and in Liquid Medium
Chitosan of different grades (LMW, HMW, and PG) were prepared as 20 mg mL
−1 stock solutions in 100 mL of distilled water (pH 7.0) and the pH was adjusted with dilute acetic acid to 5.6 [
35]. Working concentrations were chosen based on previous experiments, with 2 mg mL
−1 of HMW chitosan appearing to be the highest soluble concentration in plate assays. After stirring the chitosan stock solutions over night at RT, they were used to prepare PDA plates with a final concentration of 2 mg mL
−1 of chitosan. As a control condition, PDA was supplemented with the same amount acidified water, pH 5.6. A 5 mm disc containing the pathogen mycelium or
T. atroviride was placed in the center of each petri dish. The plates were incubated at 28 °C in a light/dark cycle. The radius of the colonies of the pathogens was measured under all conditions before the fungi reached the plate edge on PDA (control condition) or when sporulation was initiated. The radius of
T. atroviride was recorded after 3 and 6 days. The experiment was carried out with two biological replicates and two technical replicates, and representative pictures are shown.
In order to determine the germination efficiency, C. beticola conidia were harvested from 10-day-old plates, and ca. 2.5 × 102 conidia were plated on PDA containing 2 or 1 mg mL−1 of HMW chitosan and compared to the control condition. The plates were incubated for 3 and 6 days at 25 °C in the dark and colony-forming units from single spores (CFU mL−1) were determined.
For RNA extraction from
T. atroviride, the fungus was either grown on different chitosans or
N-acetyl glucosamine (Sigma-Aldrich). Media supplemented with glucose or glycerol were used as controls (Sigma-Aldrich). A liquid SM culture medium was used for liquid standing cultivation, as described previously [
16], and supplemented with 10 mg mL
−1 of the indicated polymers or monomers. Then, 1 × 10
6 T. atroviride spores were used to inoculate the medium. For growth on cellophane discs, PDA plates were covered with a sterile cellophane disc prior to inoculation with
T. atroviride. Mycelium was harvested after 24 h of growth at 28 °C by filtering through miracloth (Millipore/Sigma, VWR), followed by excessive washing, and frozen immediately in liquid nitrogen.
2.4. Confrontation Assays
Dual confrontation assays of
T. atroviride against
B. cinerea, S. sclerotiorum,
F. oxysporum, or
C. beticola were performed as described in [
34]. To evaluate synergistic effects between
T. atroviride and chitosan, PDA medium was supplemented with chitosan solutions of different molecular weights (HMW, LMW, PG, 2 mg mL
−1). As controls, PDA plates with an equal volume of acidified water, adjusted to pH 5.6, were used. Agar plugs (5 mm) were taken from
T. atroviride and the hosts were placed on a 94 mm petri dish approximately 50 mm apart. The growth of the hosts
B. cinerea, S. sclerotiorum, and
F. oxysporum was monitored after six days in circadian illumination at 28 °C. Due to its slow growth,
C. beticola was inoculated six days prior to
T. atroviride and measured on the twelfth day of incubation. The experiment was carried out with two biological replicates, and two technical replicates and representative pictures are shown.
2.5. In-Vitro Cultivation of B. vulgaris Seedlings and Germination Efficiency
For in vitro cultivation of B. vulgaris seedlings (cultivar: Hannibal DE068-001723319) 100 native seeds were coated for 2 h at RT with constant shaking (800 rpm), either with 10 mg mL−1 of HMW chitosan or distilled water (pH 5.6). The treated seeds were dried overnight on filter paper.
Adapted to the rules for seed testing of the International Seed Testing Association [
36], 100 seeds per condition were distributed in 5 Petri dishes (20 seeds per Petri dish) and placed on a layer of moistened filter paper. The seeds were incubated in the dark at 22 °C. The germination percentage (GP), indicating the percentage of germinated seeds after 48 h, 72 h, and 120 h (1); the germination capacity (GE, in percent), indicating the germination efficiency per day (2); and the germination index (GI, in percent), as a mean of the total germination capacity over time (3), were examined [
36]. For calculation purposes, the below formulas were used, where A is the total number of seeds, and B, C, and D are the number of seeds germinated after 48 h, 72 h, 120 h, respectively. F is the number of days of seed germination.
Sterile conditions were used to cultivate seedlings for RNA extraction. For this purpose, the seeds were surface-sterilized with a 70% alcohol solution for 5 min, followed by further sterilization without prior rinsing with a sodium hypochlorite solution (0.2% BayroChlorit) diluted in distilled water and 4 drops of Tween-20 (in 100 mL). After 20 min of manual shaking, the seeds were rinsed three times with sterile, distilled water and coated either with 10 mg mL−1 of chitosan, a 104 T. atroviride spores mL−1 solution containing 10 µL mL−1 of glycerol, or distilled water pH 5.6. Five coated seeds were placed 25 mm apart in the upper quarter of a square Petri dish with a length of 120 mm filled with 0.6% phytagel, supplemented with 10 g L−1 sucrose, 0.4 g L−1 CaCl2·2H2O. The seeds were preincubated at 4 °C in complete darkness for 48 h.
The cultures were grown at 24 °C with a 12 h/12 h circadian rhythm. Seedling material was harvested from roots and shoots of every condition after 10 days of incubation, and material was immediately frozen in liquid nitrogen and stored at −80 °C for RNA extraction. The experiment was repeated twice.
2.6. Greenhouse Pots Experiment of B. vulgaris and C. beticola Infection
The plants were grown on a conventional peat-based pot mix in a small greenhouse test setup over a period of 3 months from May to August 2021 without additional heating or light. The average perennial (1981-2010) monthly temperature and hours of sunshine for the region around Wiener Neustadt (local experiment) are as follows: May—15.2 °C and 229 h; June—18 °C and 228 h; July—20.2 °C and 250 h; and August—19.8 °C and 239 h. During the test period, the monthly average temperature was −1.5 °C lower in May and +3.6 °C lower in June and July, compared to the annual average. In the greenhouse experiment, an irrigation scheme with 100 mL of tap water was carried out every second day. To investigate the growth and/or defense stimulating effects of each treatment, the effects of all agents and control condition were preventively sprayed on whole plants.
Seeds were germinated in small containers and transplanted after 2 weeks (2-cotyledon stage) to larger pots (one plant per pot), with 180 mm diameter. Seedlings were then cultivated for 3.5 more weeks to the six-leaf stage. The treatments were applied to six expanded beet seedlings obtained from cultures selected on the basis of their synchronized cotyledon developmental stage. At the age of 37 (t1), 57 (t2) and 70 (t3) days, plants (n = 6) were treated with a hand sprayer (volume of 1 l). The plants were sprayed with 10 mL per plant from the following preparations: 1 mg mL−1 of HMW chitosan (CHSN, Sigma-Aldrich; pH 4.5), freshly harvested T. atroviride spores from a 7-day-old culture on PDA (TA.SP, 4 × 104 spores mL−1), or distilled H2O as control (acidified with acetic acid, pH 4.5). Twenty and thirteen days after treatment (t1 and t2, respectively), one leaf was collected from each plant and leave tissue was harvested for RNA extraction and expression analysis. Consequently, photographs were taken for visual assessment of vigor and strength. Growth promotion, vitality, and frass were documented.
Seven days after the third treatment, all plants were inoculated with a freshly prepared spore solution of
C. beticola. The spores were obtained by adding 10 mL of sterile distilled water to a petri dish containing a 10-day-old culture of
C. beticola, which was then scraped off with a Drigalski spatula, and the spore concentration was adjusted to 10
4 spores mL
−1. After spraying each plant with 10 mL of spore solution, the plants were covered with transparent polyethylene bags (50 cm × 100 cm) to maintain humidity. The severity of the disease was determined 2 and 3 weeks after the inoculation. The disease severity and degree of invasive growth of CLS were documented by means of photography and visual assessment of the developed leaf spots and frass. Disease incidence was assessed as described:
2.7. Leaf Disc Assay for the In Vitro Assessment of CLS Disease
The in vitro leaf disc assay was performed essentially as described. Adult plants at the 8-leaf stage were treated with 1 mg mL−1 of HMW chitosan 24 h prior to the assay start. Leaf discs with a 10 mm diameter were cut from the leaves, placed with the upper surface facing upwards on water agar (0.5%), and sprayed with a 104 spores mL−1 solution of freshly harvested C. beticola spores. The plates were sealed with parafilm and incubated at 22 °C in a light/dark cycle for 14 days. The disease severity on each leaf disc was evaluated by counting the number of spots per leaf disc according to a scale with five categories: A = discs with no CLS disease; B = discs with little disease (up to 5 spots); C = 6–10 CLS per disc; D = 11–20 CLS per disc; and E = leaf disc covered entirely with spots. The number of discs for each category was assessed for CHSN-treated and control leaves.
2.8. RNA-Extraction and cDNA Amplification
For RNA extraction from
T. atroviride ca. 100 mg of mycelium were ground to a fine powder with glass beads (2 beads with a diameter of 2.85–3.45 mm and 200 µL of beads with a diameter of 0.75–1.0 mm) and a bead mill (2 × 60 s at 6 m/s; Bead Ruptor 24 Elite Bead Mill Homogenizer, Omni International, VWR). For samples from
T. atroviride grown on chitosans, the total RNA was extracted using an extraction protocol adapted by [
37] suited for RNA recovery from samples grown on agar to reduce binding of chitosan to the RNA. For RNA extraction from
T. atroviride, samples grown on other carbon sources (glucose, GlcNAc, glycerol), on cellophane discs, or isolated from
B. vulgaris seedling roots, the QIAGEN RNeasy Mini Kit for plant and fungal tissue, including the QIAshredder
® cell-lysate Homogenizers (QIAGEN N.V.), was used. For RNA extraction from plant material, either ca. 100 mg of frozen
B. vulgaris roots or shoots from seedlings (usually 3-4 seedlings) or a leaf area corresponding to ca. 100 mg were ground to a fine powder in a bead mill (1 × 60 s at 3200 m/s) using 2 stainless steel beads (diameter 3 mm). The QIAGEN RNeasy Mini Kit was used to extract RNA. RNA was treated with DNAse I and purified with RNA GENEJet Micro-Cleanup kit (Thermo Fisher Scientific, Waltham, MA, USA), and the RNA quality was evaluated for purity and integrity with the TECAN NanoQuant Plate™ (Tecan Group Ltd. Männedorf, Switzerland). cDNAs were generated from 1 µg of RNA with the Revert Aid H-minus cDNA synthesis kit (Thermo Fisher Scientific, Waltham, MA, USA).
2.9. Gene Expression Analysis
For gene expression analysis of
T. atroviride cultured on chitosan of different molecular weight and control substrates, or isolated from
B. vulgaris seedling roots or cellophane, RT-PCR reactions were performed, using GoTaq
® DNA Polymerase from Promega (Promega Corporation) and a T100 Thermal Cycler (Bio-Rad), as described previously [
38]. The primer pairs are described in
Table S1. PCR products were analyzed by agarose gel electrophoresis using a Gel Doc™ system (Bio-Rad).
For gene expression analysis of
B. vulgaris seedlings and young plants, RT-qPCR reactions were performed in a Rotor-Gene 6000 (QUIAGEN N.V.) as described previously [
39]. Relative gene transcript levels were quantified and normalized to the corresponding signals of the
B. vulgaris housekeeping genes ACT7, TUB1, and GAPDH. All primers are listed in
Table S2. The fold change relative to the control conditions was calculated using the ΔΔCT method with REST software [
40].
2.10. Microscopic Analysis
Strains grown on PDA or PDA with 0.6 mg mL−1 of LMW chitosan were applied in a droplet of 30 μL of water with the inverted agar method and imaged with an inverted Zeiss Axio Observer Z1 (Zeiss, Oberkochen, Germany) with differential interference contrast optics.
2.11. Statistical Analysis
Statistical analysis for RT-qPCR was performed with REST software with a pair-wise fixed reallocation randomization test. At least six biological and three technical replicates were used for statistical analysis of RT-qPCR data. For evaluation of the germination ability of C. beticola, statistical analysis was performed using Poisson distribution. For all other statistical analyses the Student’s t-test was used, assuming unequal variance of groups.
4. Discussion
C. beticola causes one of the most important and devastating leaf diseases in the plant industry worldwide [
24,
25], whereby CLS disease is a particular burden for sugar farmers and thus also for exploitation in the processing industry in Austria and Europe. The frequent application of fungicides, mainly of chemical-synthetic origin, continues to be the primary means of combating CLS disease. An effective way to combat disease is to generate hybrid species with increased genetic resistance, though they might have lowered yields or decreased final product quality. Not least in order to conform to the rules of the Sustainable Development Goals (SDG 2030), efforts have been made in recent decades to promote sustainable BCA.
In this study, we examined and compared two of these promising alternatives to common fungicides, namely the biocidal natural product chitosan and the BCA
T. atroviride IMI206040. Our results confirmed their high potential in plant growth promotion of
B. vulgaris and provided new insights into the strong reduction in CLS disease. Our results demonstrate that LMW and HMW chitosan at a concentration of 2 mg mL
−1 in solid-plate assays are highly effective against a variety of important fungal crop pathogens, including four
Fusarium spp., two
Penicillium spp.,
B. cinerea, and
C. beticola. This is in line with other recently published findings on fungal pathogens, including
F. oxysporum [
44] and other
Fusarium spp.,
B. cinerea,
Rhizopus spp.,
Phytophthora spp., and
Alternaria spp. [
45].
R. solani showed only a 20% inhibition by all grades of chitosans, which confirmed the findings described in [
46]. Only
Aspergillus spp. were not strongly affected by any of the chitosans in our
in vitro assay, although an inhibition by COS has been described [
47]. The comparison of the three different chitosan grades enabled us to select the most effective among all the pathogens examined. PG chitosan showed the least efficacy, but LMW and especially HMW chitosan turned out to be the most promising biocidal agents with high fungicidal effects on almost all selected pathogens important for agriculture (food spoilage, horticulture, post-harvest processing). Inhibition of between 80% and nearly 100% for
C. beticola and all
Fusarium spp., respectively, was observed. Previous studies showed improved antifungal efficacy of chitosan oligomers on some fungi that increase with polymer size [
48]. The strong biocidal effect of chitosan leads to hyphal agglomeration in
F. oxysporum solid cultures [
45], which we also confirmed microscopically in this work. In general, negative autotropism allows the fungus to explore and adapt to the existing substrate, while subapical parts of the hyphae form new branches. Chitosan could form an impermeable polymer layer that changes cell permeability and prevents nutrients from entering the cell. This can lead to a loss of hyphal avoidance and, thus, a reduced perception and utilization of the available substrate, which leads to loss of the negative autotropism. Due to the lack of nutrient absorption, which is prevented by chitosan (see hyphal bundles,
Supplementary Figure S1), hyphae stop growing and, therefore, show abnormal shapes.
C. beticola shows reduced germination on plates containing chitosan with hyphae showing a short, narrowed growth phenotype that indicates a strong growth inhibition by chitosan. This results in a dense network of hyphae with a short, nodular, and concentric phenotype. Thus, microscopic data confirmed the strong growth inhibition of chitosan for both severe pathogens.
One important trend in biocontrol is the application of combinations of BCAs or mixing a BCA with a biocidal natural agent [
21,
23]. Evaluating their potential synergism, additive effects, or antagonism before application is important since a shift towards increased, reduced, or similar effectiveness determines their best way of application and combination. To this end, we started to investigate how chitosan affects the mycoparasitic behavior of
Trichoderma in vitro.Interestingly, in a confrontation assay for a combined activity of chitosan and
T. atroviride, we observed a strong synergistic effect for the growth inhibition of momentous plant pathogens, including
C. beticola and
F. oxysporum. The combination of HMW chitosan with
T. atroviride induced the most stable fungistasis in
C. beticola, increasing by 17% to an almost total inhibition of 93%. To the best of our knowledge, our study is the first report on the use of
T. atroviride as an efficient mycoparasite for
C. beticola biocontrol. It is also important that the otherwise weaker inhibition by PG chitosan could be significantly increased in the combined confrontation assay for all investigated pathogens. The weaker inhibition is most likely due to its less defined nature, and the increase in inhibition is thus mainly due to the presence of
T. atroviride and only a small additive effect of the PG chitosan itself. We assume that an additive effect caused by chitosan triggers an increased production of secreted hydrolytic enzymes in
T. atroviride and, thus, other potential effectors, which renders it more aggressive towards phytopathogens. Indeed, the mRNA levels for four secreted chitosanases and a chitin deacetylase, which we also recently identified as highly upregulated after contact with host pathogens [
16], were strongly elevated. Furthermore, important mycoparasitism marker genes, such as
ech42 and
nag1, were upregulated. Based on these results, we believe that the chitosan polymers mimic the presence of a potential host for the antagonist
T. atroviride, thus triggering the production of a subset of secreted enzymes that enable parasitism and killing of the host, which might also explain why
T. atroviride can adapt to growth on chitosan. Chitosan inhibits the host due to a direct biocidal mechanism, while growth inhibition by the presence of
T. atroviride is most likely due to secretion of secondary metabolites and enzymes after sensing of the host [
16]. To this end, chitosan might increase the susceptibility of the hosts to the indirect antagonistic attack by a BCA.
Since especially HMW chitosan proved highly effective against the majority of investigated plant pathogens, we were also interested in the impact of HMW chitosan on the sugar beet cultivar
B. vulgaris. HMW CHSN, an elicitor of defense mechanisms in plants, has been shown to promote pathogen resistance and growth (reviewed in [
1]).
T. atroviride IMI206040 can synthesize IAA [
49] or volatile organic compounds (mVOCs), e.g., 6-pentyl-2H-pyran-2-one (6-PP), which are described in promoting plant growth [
50].
We designed a greenhouse pot experiment with three treatments of foliar spray over a period of 40 days with chitosan or
T. atroviride IMI206040 spores on young
B. vulgaris plants in the six-leaf stage. The
T. atroviride spore-treated plants, and especially the chitosan-treated plants, showed significantly promoted growth and vigor, with intensified leaf color and larger leaf area. Importantly, every treatment increased the observed positive effects on plant health.
Trichoderma application increases the tolerance to abiotic stress (reviewed in [
7,
13]), such as drought [
11] and salinity stress [
51]. The plants in the greenhouse experiment faced high temperatures during July and August, and chitosan treatment has been shown to improve tolerance to heat stress as well [
52].
In plants treated with chitosan, the elicitation of phytoalexin and phenolic precursors, an increased production of chitinases, and reduced levels of aflatoxin together with other factors relevant for plant defense have been described [
1,
2]. Notably, a successful test for preventive chitosan treatment of table beet to decrease CLS was carried out recently [
33]. Moreover, foliar spray with
Trichoderma spp. isolated from sugar beet fields reduced the disease incidence by
C. beticola in sugar beet [
28]. Strikingly, in our greenhouse experiment, the repeated foliar application with either
T. atroviride spores or chitosan elicited defense responses in
B. vulgaris and considerably reduced CLS. The plants primed with chitosan were 47% less infected and the
T. atroviride spore group was 27.9% less infected by CLS, and the CLS tissue was less necrotic than in the control group. Apart from eliciting defense responses in plants, chitosan itself exerts high, intrinsic, antifungal activity (reviewed e.g., [
1]), which was also confirmed with the leaf disc assay and the
in vitro germination assays for
C. beticola. We propose that a simple application of repeated foliar spray with the potent antifungal and defense-inducing agent chitosan is sufficient to considerably reduce CLS in sugar beet.
We would also like to draw the attention to an additional observation, that the strongly compromised control group showed signs of a generally increased susceptibility to frass by herbivorous insect pests, i.e., leaf miner damage. Almost no damage by insect pests was seen in the chitosan or
T. atroviride spore-treated groups. A similar effect was reported in chitosan coated soybeans against
Agrotis ipsilon, soybean capsule borer, and soybean aphid [
36].
Our first trials with both active ingredients had a positive effect on the development, growth promotion, and induction of systemic resistance in
B. vulgaris. We further show that, instead of inoculating the soil with
T. atroviride spores, foliar spray triggers the defense mechanism of
B. vulgaris and also strongly increases resistance towards invasion by the most notorious pest
C. beticola. We confirmed that foliar application of young plants with either
T. atroviride spores or 1 mg mL
−1 of HMW chitosan, resulted in priming for a future attack, indicated by a stable induction of the expression of a pathogenesis-related gene (PR-3), a basic class IV chitinase, weeks after application. A systemic induction of chitinase activity in sugar beet leaves after treatment with different
Trichoderma isolates was connected to a reduction in CLS disease, as noted previously [
28].
By contrast, the acidic class III chitinase (SE2) and a basic GH17 beta-1,3-glucanase (GLU2) were downregulated with both agents. Nielsen 1994 [
53] showed that, in sugar beet, the induction of some PR proteins, including the chitinase SE2 and glucanase GLU2, is in contrast to other plants not correlated with the induction of resistance. Furthermore, GLU2 has been identified as a strong but late responder, only directly at sites of necrosis caused by
Cercospora infection [
54].
Interestingly, only chitosan enhanced the expression of additional defense-related pathways by increasing levels of PAL (phytoalexin synthesis) and oxidative stress-related genes (GST and DMRL) as defense mechanisms. In this context, it is important to mention that chitin-specific receptors in plants recognize chitin and its derivatives when they are released by interaction with fungal pathogens, which then elicit defense responses. Accordingly, a chitin-based treatment activates a defense mechanism in plants, mimicking the attack by a pathogen [
55]. Chitin elicitor binding proteins (CEBiP) isolated from several crops affect the chitosan-responsive differential gene expression profile and, thus, defense responses directly [
56]. These mainly include phytoalexin biosynthesis (hypersensitive response, HR), which involves the participation of enzymes of phenylpropanoid metabolism, i.e., phenylalanine ammonia lyase (PAL) and chalcone synthase (CHS) [
9]. PAL is involved in the synthesis of aromatic secondary metabolites e.g., phytoalexins, and may thus directly contribute to disease resistance in hypersensitive response (HR) [
9,
13]. The induction of the PAL gene is an indicator of induced cell wall thickening and might also hint at the production of antifungal compounds, such as phytoalexins. In order to facilitate the infestation,
C. beticola directly suppresses the PAL expression in the first step of the infection [
57]. Rivera-Méndez et al. [
12] recently found evidence of the suppression of PAL expression by a fungal pathogen in bulbous plants (
Allium cepa L.) on the first day of infection with
Sclerotium cepivorum. In addition, pretreatment or simultaneous treatment with a
T. asperellum isolate (BCC1) induced PAL expression, even if the induction was not stable over a long period of time. Our experiments provide evidence that the systemic resistance induced by chitosan treatment leads to increased PAL expression, which could significantly reduce the incidence of CLS, by cell wall thickening and/or phytoalexin production. Notably, overexpression of PAL in tobacco resulted in increased production of the phenylpropanoid compound chlorogenic acid and reduced susceptibility to infection with
Cercospora nicotianae [
58,
59].
Cercosporin, produced by
C. beticola, when exposed to light leads to the production of reactive oxygen species (ROS). ROS, in turn, are used by
C. beticola to break down plant cell membranes [
60]. The increase in antioxidant gene expression (increased GST and DMRL transcription) observed in our experiments is a strong indication for detoxification of the generated ROS in
B. vulgaris treated with HMW chitosan. In addition, peroxidases can use ROS to increase lignin and, thus, cell wall thickness by oxidizing phenolic compounds [
61].
Seed coatings provide protection during the first stages of germination and seedling development, where the seeds and seedlings are most vulnerable and may not be fully capable of protecting themselves from pathogens. Above all, chitosan, with its film-forming, viscous properties [
21], is also ideally suited for coating. Using radio-labelled chitosan, it has further been shown that chitosan can be translocated to the emerging seedling [
62].
Positive effects of chitosan on germination, growth, and plant health have been described previously for several plants; however, to our knowledge,
B. vulgaris seed coating with chitosan has not been investigated so far [
4]. In a filter paper assay with coated
B. vulgaris seeds, we observed a positive impact of HMW chitosan on germination onset and germination efficiency compared to the control condition. After 5 days in the dark, an increase in total germination of 15% compared to the control group was observed. We speculate that a long-lasting effect, resulting in increased beet development and weight, might positively affect sugar yield. Despite the strong growth promotion, we could not find any differences in the expression profile of defense genes of the seedlings. Expression analysis of a different set of genes, such as those related to nitrogen metabolism, or to regulation of developmental hormones, including abscisic acid and auxin, could help to identify the underlying mechanism of growth promotion in seedling development. Interestingly, different developmental stages and tissues might benefit differently from the seed coating with chitosan, but resulted in increased over all germination efficiency and perhaps general development.
Interestingly, when the growth medium was supplemented with 1 mg mL
−1 of chitosan, instead of coating with HMW chitosan, all screened defense-related genes were highly upregulated in the roots, but only PR-3 expression was induced in the shoots of the seedlings, suggesting induced systemic resistance in the above-ground parts. A stronger root hair development and a shorter stunted growth of the radicle were observed in these seedlings (data not shown). The shorter roots might be a tradeoff for the stronger root hair formation, which might in turn increase nutrient mobilization and growth promotion of the seedling in later growth periods.
Arabidopsis root colonization by
P. indica resulted in a stunted but highly branched root system, which was probably mediated by low amounts of auxins produced by
P. indica [
6].
Trichoderma spp. are mainly used as pre-planting applications for seed coatings and, similar to our data with chitosan coating, have been shown to improve germination of a variety of plants, their vitality index, and defense mechanism [
5]. The seed coating of
B. vulgaris with
T. atroviride spores in our experiments had a positive influence on the defense-related gene expression. Some
Trichoderma species are able to penetrate the epidermis and establish long-lasting colonization of the root surfaces, which, in turn, leads to changes in the plants metabolism and expression profile [
5]. We noticed that
T. atroviride had established colonization on the roots and lower parts of the hypocotyl of the seedlings, while no growth was observed on the shoots surface (data not shown). Notably, we detected an increased expression of
epl1, an indicator for communication with the plant [
19], in
T. atroviride isolated from these roots. EPL1 is highly similar to cerato-platanins, which have been implicated in plant pathogenesis and in the elicitation of plant defense responses. In addition, the whole set of investigated defense-related genes, except for PAL, was highly upregulated in roots and shoots of
B. vulgaris, by the presence of the BCA, suggesting activation of the defense-related machinery against pathogens, but reduced lignification to facilitate entry of the BCA. This might be due to the stress generated by the strong colonization of
T. atroviride of the roots in the sterile culture.
Our data suggest that CHSN is an excellent candidate to replace or assist common fungicides by promoting seedling germination, growth, and plant health, as well as inducing multiple systemic resistance. We were able to show how chitosan, in particular, has a biocidal, immune-stimulating effect, while
T. atroviride spores mainly induced expression of a stress-related defense gene in
B. vulgaris. The incidence of CLS disease was effectively reduced by priming with chitosan and, to a lesser extent, by
T. atroviride spores in foliar application, but both active substances revealed a pronounced insect-repellent effect. We assume a synergistic effect of
T. atroviride and, in particular, of HMW chitosan on the inhibition of relevant
B. vulgaris pathogens due to an enhanced expression of mycoparasitism-associated enzymes. Both agents could also act synergistically across different signaling pathways, which could be of great advantage for their combinatorial (and, thus, complementary) application. The mechanisms of the perception of chitosan by plants and their induced resistance have not yet been elucidated, but it is known that the expression of RLK genes is induced in various plant species and the mitogen-activated protein kinase (MAPK or MPK) is activated. In addition, the chitin receptor AtCERK1 binds weakly to chitosan (reviewed in [
63]). In the signal transduction mediated by the plant defense system, MAPK cascade signal networks also play an essential role in establishing resistance to pathogen defense, in particular the MPK3, MPK4, and MPK6 cascades [
64]. It would, therefore, make sense to identify the differences with greater precision.
Notably, a combined use of CHSN and Trichoderma spores also demands caution, as also only a small mutual inhibitory effect of both agents could affect disease efficacy. To this end, data on experiments in dual applications need to be considered. Nevertheless, an alternating application appears to be more successful towards a possible complementary function in signaling pathways. Moreover, concentration and strong-sensitivity fluctuations of the beneficial soil microbiome should be considered and empirically determined in further in vitro assays as major decisive factors for plant treatments.
In summary, it is thus conceivable that spraying Trichoderma spp., in combination with exogenous chitosan, may be used as a powerful tool to enable crop control. Taking into account the fact that a frequent change in fungicides can bypass pathogen resistance but trigger plant defense reactions, the combined or alternating applications of these BCAs would be a fascinating new tool, which we will investigate in detail in further studies.